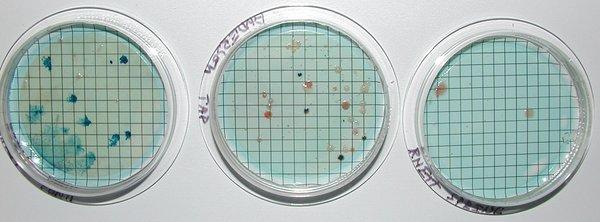

There is a terrible odor coming from this place and as a resident of a nearby neighborhood it is unbearable. Many people in my neighborhood have called to file complaints regarding the smell but...
Fitzgerald Creek Waste Water Treatment Facility
Closed
(1)
260 Colemans Bluff Dr
Woodstock, GA 30188
Fitzgerald Creek Waste Water Treatment Facility is a specialized facility in Woodstock, GA that focuses on the treatment and processing of wastewater from various sources. With a commitment to environmental sustainability, the facility utilizes advanced technologies to ensure the safe and efficient treatment of wastewater.
Operating with a team of experienced professionals, Fitzgerald Creek Waste Water Treatment Facility plays a crucial role in maintaining the cleanliness and health of the local environment by effectively managing and treating wastewater in compliance with regulatory standards.
Generated from their business information
Also at this address
See a problem?
You might also like
Partial Data by Foursquare.